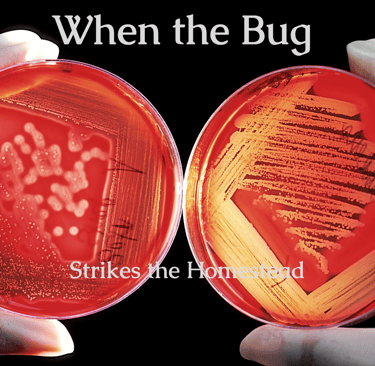

When the Bug Strikes the Homestead
Strep Throat. A bacterial infection that is inconvenient at least and potentially fatal at it's worst
HERBAL MEDICINE
Bjarni
3/24/20246 min read

This past Wednesday, was my 60th birthday. Gods 60 years on Midgard. This past Saturday, the entire family here in South Carolina were meeting up in Charleston to go to my favorite restaurant, (Inserting free plug here!) Rancho Lewis on King Street in Downtown Charleston. If you are form the southwest and either visiting or live here, you MUST eat there. The only REAL Southwestern Mexican food in the south that we have found. And REAL western BBQ, Not saying that the BBQ here is not good. But when you're from the Southwest and grew up on mesquite smoked brisket and ribs with only salt pepper and garlic as the rub then you're in for a treat.
Umm sorry was drooling on the keyboard.
We were supposed to go there for dinner, and my wife wakes up not feeling good. She is hoarse, sore throat, and generally not well. I take a look at her and throat has that lovely white coating, red and inflamed tonsils. (Don't worry I'll spare any images of that!) I ask her, "do you want to go to urgent care and get treated?" She says no.(It's a 40 minute drive to the nearest city with urgent care. ) She then says "You know how to treat this" And no time for the disclaimer. Remember we are not doctors nor can we prescribe nor treat anything for anyone. This is educational only. If things go bad, even strep can be dangerous. Normally it runs it's course on it's on in about 7 days or so. But there are times that it can spread and even turn into scarlet fever. Without knowledgeable herbal healers prior to antibiotics it could be and was a dangerous to even fatal infection. Proper and fast treatment make the difference.
We've known about strep for thousands of years In the 4th century BC, Hippocrates described Scarlet Fever and treated it somewhat successfully, but it wasn't until the 20th century that antibiotics came to play that strep was beaten. And yes antibiotics are the first choice in the 21st century for treatment of strep, and the prevention of Scarlet Fever.
As I said earlier most cases of strep clear up on their own in a bit over a week. That week is miserable but survivable. Focus should be on preventing it's spread and comfort for the patient. Now to satisfy the FDA rules,
None of the treatments outlined here are intended to diagnose, treat, cure, or prevent any disease. This is educational and use at your own risk discussion.
There are a good supply of herbal treatments for strep. But I'll say it right now, I put her on Augmentin. Why that particular one? And why an antibiotic when I'm a herbal instructor? First Augmentin is a first line choice of strep throat. 2nd it works very well on those versions that are becoming resistant to the standard Bacitracin and Erythromycin antibiotics. And she has other active issues that Augmentin is used for. For the final question, why even use it? If you know me you know that yes I support herbal medicine. Have for decades. I teach it and use it daily. I use to help others that have no other access to medicine. And I also say, if you have access to moder medications USE THEM. In an upcoming article we'll discuss the kit we have. Oh yes you can now buy a kit. Legal, Prescribed with instructions and MD support. The one we have is the Duration kit. It has a bit more than the kit from Jase for a few bucks more.
FTC Disclaimer Our site contains product affiliate links. We may receive a commission if you make a purchase after clicking on one of these links. By doing so it does not increase the price nor how awesome the product is.
The Herbs
But for the herbal treatment, I used it to help the antibiotics with their job and to do things they can't Soothe her sore throat. Menthol cough drops work okay, but they can make the pain worse before it get's better, I used a mix of Barberry Root, Marshmallow root Honey and Chamomile.
Barberry and its relative Oregon Grape Root have a chemical called Berberine. Berberine is an isoquinoline quaternary alkaloid, and medical studies has shown it to be a promising antibiotic adjuvant due to its ability to enhance the effectiveness of conventional antibiotics against drug-resistant bacterial strains. (Dove Press) That is why I choose the Barberry root. The marshmallow root contains mucilage, that coats the throat and helps soothe the throat lessening pain. And the Chamomile is a twofold. First it's well known that a cup of Chamomile tea before bed helps to relax you a bit and encourage good sleep. And what not as many people know it has anti inflammatory properties that may help bring down the swelling. This helps with swallowing and getting the rest needed. Honey of course, to first help make this taste better, barberry is bitter, and honey itself has huge antimicrobial properties. NOTE In keeping with the FDA warnings, it is not recommended to give raw honey to babies and young toddlers. I have to say that!
Preparation
You'll notice that there are multiple main components to this mix. 2 roots, one flower and honey. To get the most out of each and not damaging the delicate flowers or honey it has to be prepared in steps. These steps can I use can be found in an old friend of mines book Preppers Natural Medicine by Catherine Ellis
First the "hard" parts. The Barberry and Marshmallow roots. @ 1 onunce by weight of each to 2 cups cold water. Bring to a boil for @ 10 minutes then turn to a simmer for about 20 minutes. Reduce it by half. This is a decoction.
For the Chamomile flowers. Take about 1 teaspoon of the flowers to a cup of water that was brought to a boil then removed from the heat. I lightly crush the flowers before adding them to the tea ball. Cover the pot tightly to prevent the essential oils from escaping. Steep for at least 10 minutes.
Blending
I strained both teas with a strainer lined with a paper towel to remove the large bits and pieces.
Then to the warm liquid blended in 3 tablespoons of honey to the mix. The final yield I made for my wife was about 2 pints. This I stored in the fridge and served about a cup 3 times a day. A suggestion I got for the next batch is to add in some willow bark for its analgesic properties.
As of today she is feeling a bit better, due to both methods I used with her. Keep a close eye on folks with strep. If they show little to no improvement after 36-48 hours it's time for a trip to the doctor and a culture of the throat. You may be dealing with a resistant for, And before taking the recipes from anyone on the net or even a friend, know the hazards and potential side effects of the herbs used. You do not give someone an herb with out getting at least a history of any allergies to foods and medications. Seriously, Herbal medicine is as dangerous used incorrectly as western medicine. Do not let the "Oh it's safe because it's natural" tripe fool you. Arsenic is natural. Poison Ivy is natural. Take the time to learn what to do how to do it and when to do it and the when to know when you just are out of your league.
Next time I'll update y'all on how she progressed through this.
And Cat Ellis's book. We have 2 -3 copies of it. One on the bookshelf. and at least one vacuumed sealed and in a Bug Out Box of herbal stuff. Buy it, It's well worth the few bucks for it.











